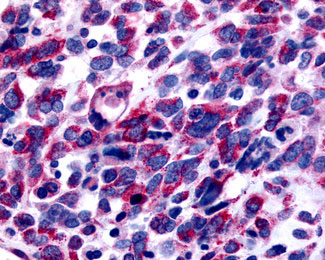

> Antigen, Antibodies, ELISA, Western Blot > Primary Antibody > Polyclonal Antibodies > GPER1 / GPR30 Antibody (Cytoplasmic Domain)Brand |
Leading Biology | Catalog Number |
AMRa00045G |
Product Type |
Polyclonal Antibodies | Field of Research |
|
Product Overview |
We constantly strive to ensure we provide our customers with the best antibodies. As a result of this work we offer this antibody in purified format.
We are in the process of updating our datasheets. If you have any questions regarding this update, please feel free to contact our technical support team.
This product is a high quality GPER1 / GPR30 antibody (Cytoplasmic Domain).
|
||
Molecular Weight |
42kDa
|
||
Cellular Localization |
Antigen Cellular Localization:
Nucleus. Cytoplasm. Cytoplasm, perinuclear region. Cytoplasm, cytoskeleton. Cell membrane; Multi- pass membrane protein. Basolateral cell membrane; Multi-pass membrane protein. Cytoplasmic vesicle membrane; Multi-pass membrane protein. Early endosome. Recycling endosome. Golgi apparatus membrane; Multi-pass membrane protein. Golgi apparatus, trans-Golgi network. Endoplasmic reticulum membrane; Multi-pass membrane protein. Cell projection, dendrite. Cell projection, dendritic spine membrane; Multi-pass membrane protein. Cell projection, axon. Cell junction, synapse, postsynaptic cell membrane, postsynaptic density Mitochondrion membrane; Multi-pass membrane protein. Note=Colocalized with BSN to the active zone of presynaptic density. Colocalized with DLG4/PSD95 and neurabin-2 PPP1R9B in neuronal synaptosomes (By similarity). Endocytosed in a agonist- and arrestin-independent manner. Colocalized with RAMP3 and clathrin-coated pits at the plasma membrane. Colocalized with transferrin receptor at the plasma membrane and perinuclear region. Accumulated and colocalized with RAB11 proteins in recycling endosomes and trans-Golgi network (TGN), but does neither recycle back to the cell surface nor traffics to late endosome or lysosome. Colocalized with calnexin in the endoplasmic reticulum. Traffics to intracellular sites via cytokeratin intermediate filaments like KRT7 and KRT8 after constitutive endocytosis in epithelial cells. Colocalized with EGFR in the nucleus of agonist-induced cancer-associated fibroblasts (CAF)
|
||
Host |
Rabbit
|
||
Species Reactivity |
Human
|
||
Target |
Human GPR30. BLAST analysis of the peptide immunogen showed no homology with other human proteins.
|
||
Symbol |
CEPR, CMKRL2, DRY12, GPER, GPR30
|
||
GeneID |
|||
UniProt ID |
|||
Function |
G-protein coupled estrogen receptor that binds to 17- beta-estradiol (E2) with high affinity, leading to rapid and transient activation of numerous intracellular signaling pathways. Stimulates cAMP production, calcium mobilization and tyrosine kinase Src inducing the release of heparin-bound epidermal growth factor (HB-EGF) and subsequent transactivation of the epidermal growth factor receptor (EGFR), activating downstream signaling pathways such as PI3K/Akt and ERK/MAPK. Mediates pleiotropic functions among others in the cardiovascular, endocrine, reproductive, immune and central nervous systems. Has a role in cardioprotection by reducing cardiac hypertrophy and perivascular fibrosis in a RAMP3-dependent manner. Regulates arterial blood pressure by stimulating vasodilation and reducing vascular smooth muscle and microvascular endothelial cell proliferation. Plays a role in blood glucose homeostasis contributing to the insulin secretion response by pancreatic beta cells. Triggers mitochondrial apoptosis during pachytene spermatocyte differentiation. Stimulates uterine epithelial cell proliferation. Enhances uterine contractility in response to oxytocin. Contributes to thymic atrophy by inducing apoptosis. Attenuates TNF-mediated endothelial expression of leukocyte adhesion molecules. Promotes neuritogenesis in developing hippocampal neurons. Plays a role in acute neuroprotection against NMDA- induced excitotoxic neuronal death. Increases firing activity and intracellular calcium oscillations in luteinizing hormone- releasing hormone (LHRH) neurons. Inhibits early osteoblast proliferation at growth plate during skeletal development. Inhibits mature adipocyte differentiation and lipid accumulation. Involved in the recruitment of beta-arrestin 2 ARRB2 at the plasma membrane in epithelial cells. Functions also as a receptor for aldosterone mediating rapid regulation of vascular contractibility through the PI3K/ERK signaling pathway. Involved in cancer progression regulation. Stimulates cancer-associated fibroblast (CAF) proliferation by a rapid genomic response through the EGFR/ERK transduction pathway. Associated with EGFR, may act as a transcription factor activating growth regulatory genes (c-fos, cyclin D1). Promotes integrin alpha-5/beta-1 and fibronectin (FN) matrix assembly in breast cancer cells.
|
||
Summary |
G-protein coupled estrogen receptor that binds to 17- beta-estradiol (E2) with high affinity, leading to rapid and transient activation of numerous intracellular signaling pathways. Stimulates cAMP production, calcium mobilization and tyrosine kinase Src inducing the release of heparin-bound epidermal growth factor (HB-EGF) and subsequent transactivation of the epidermal growth factor receptor (EGFR), activating downstream signaling pathways such as PI3K/Akt and ERK/MAPK. Mediates pleiotropic functions among others in the cardiovascular, endocrine, reproductive, immune and central nervous systems. Has a role in cardioprotection by reducing cardiac hypertrophy and perivascular fibrosis in a RAMP3-dependent manner. Regulates arterial blood pressure by stimulating vasodilation and reducing vascular smooth muscle and microvascular endothelial cell proliferation. Plays a role in blood glucose homeostasis contributing to the insulin secretion response by pancreatic beta cells. Triggers mitochondrial apoptosis during pachytene spermatocyte differentiation. Stimulates uterine epithelial cell proliferation. Enhances uterine contractility in response to oxytocin. Contributes to thymic atrophy by inducing apoptosis. Attenuates TNF-mediated endothelial expression of leukocyte adhesion molecules. Promotes neuritogenesis in developing hippocampal neurons. Plays a role in acute neuroprotection against NMDA- induced excitotoxic neuronal death. Increases firing activity and intracellular calcium oscillations in luteinizing hormone- releasing hormone (LHRH) neurons. Inhibits early osteoblast proliferation at growth plate during skeletal development. Inhibits mature adipocyte differentiation and lipid accumulation. Involved in the recruitment of beta-arrestin 2 ARRB2 at the plasma membrane in epithelial cells. Functions also as a receptor for aldosterone mediating rapid regulation of vascular contractibility through the PI3K/ERK signaling pathway. Involved in cancer progression regulation. Stimulates cancer-associated fibroblast (CAF) proliferation by a rapid genomic response through the EGFR/ERK transduction pathway. Associated with EGFR, may act as a transcription factor activating growth regulatory genes (c-fos, cyclin D1). Promotes integrin alpha-5/beta-1 and fibronectin (FN) matrix assembly in breast cancer cells.
|
||
Form |
Liquid |
||
Storage & Stability |
Store at +4°C short term. For long-term storage, aliquot and store at -20°C or below. Stable for 12 months at -20°C. Avoid repeated freeze-thaw cycles.
|
||
Applications |
IHC-P
|
||
Dilution |
IHC-P (15-20 μg/ml)
|
||
Synonyms |
G-protein coupled estrogen receptor 1, Chemoattractant receptor-like 2, Flow-induced endothelial G-protein coupled receptor 1, FEG-1, G protein-coupled estrogen receptor 1, G-protein coupled receptor 30, GPCR-Br, IL8-related receptor DRY12, Lymphocyte-derived G-protein coupled receptor, LYGPR, Membrane estrogen receptor, mER, GPER1, CEPR, CMKRL2, DRY12, GPER, GPR30
|
||
Images |
Anti-GPER1 / GPR30 antibody IHC of human Skin, Melanoma. 
Anti-GPER1 / GPR30 antibody IHC of human adrenal. 
Human, Pancreas, Islet: Formalin-Fixed Paraffin-Embedded (FFPE) |
||
Specification |
|||
Quantity |
|
||
| Select | Brand | Catalog No. | Product Name | Pack Size | Type | Field of Research | Specification | Quantity | Price(USD) | |
| 1 | Leading Biology | APR03440G | ITGA11 Antibody (N-term) | 100 μl | Polyclonal Antibodies |
|
$495.00 | Add Ask | ||
| 2 | Leading Biology | APR04537G | CMIP Antibody (C-term) | 100 μl | Polyclonal Antibodies |
|
$495.00 | Add Ask | ||
| 3 | Leading Biology | APR12422G | Human H4 Histamine Receptor (extracellular) Antibody | 50 μl | Polyclonal Antibodies |
|
$695.00 | Add Ask | ||
| 4 | Leading Biology | APR03844G | UBE2W Antibody (C-term) | 100 μl | Polyclonal Antibodies |
|
$495.00 | Add Ask | ||
| 5 | Leading Biology | APR04349G | HECTD2 Antibody (N-term) | 100 μl | Polyclonal Antibodies |
|
$495.00 | Add Ask | ||
| 6 | Leading Biology | APR03502G | IGHG1 Antibody (Center) | 100 μl | Polyclonal Antibodies |
|
$495.00 | Add Ask |
 Leading Biology Inc.
2600 Hilltop DR, Building G, B Suite C138
Richmond, CA, 94806
Tel: 1-661-524(LBI)-0262
Email: info@leadingbiology.com
Leading Biology Inc.
2600 Hilltop DR, Building G, B Suite C138
Richmond, CA, 94806
Tel: 1-661-524(LBI)-0262
Email: info@leadingbiology.com
Complete this form and click send to ask us a question, request a quote or simply say hello.

You have 0 item in your cart

You have 0 item in your inquiry list
